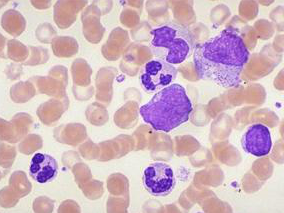
ELN建议对一线治疗慢性粒细胞白血病患管理的影响
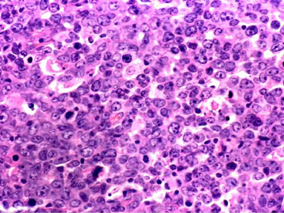
Coltuximabravtansine联合利妥昔单抗用于DLBCL患者的效果

-
ELN建议对一线治疗慢性粒细胞白血病患管理的影响
环球医学资讯
2008年03月16日
点击量:317
1小时条评论2016年7月,发表在《Br J Haematol》的一项研究调查了目前接受一线治疗的慢性期CML患者,包括治疗、监测和反应动力学。结果显示,大多数仍然接受一线治疗的患者为最佳应答,有一些被归类为在警告区或响应失败。 酪氨酸激酶抑制剂的可用性扩大了慢性粒细胞白血病(CM...
-
R-BL方案用于不适合蒽环类或强化挽救方案的侵袭性B…
环球医学资讯
2016年07月29日
点击量:159
1小时条评论患有侵袭性淋巴瘤的老年人热群越来越大。2016年7月,发表在《Br J Haematol》的一项研究显示,对于不适合标准积极治疗方案的初始治疗或复发/难治性侵袭性淋巴瘤老年患者,利妥昔单抗-来那度胺-苯达莫司汀(R-BL)方案可以考虑作为一种治疗选择。 越来越多的老年患者...
-
低肿瘤负荷惰性淋巴瘤:利妥昔单抗维持治疗vs重新给…
环球医学资讯
2016年07月27日
点击量:393
1小时条评论2016年6月,发表在《Br J Haematol》的一项3期随机前瞻性研究对利妥昔单抗维持治疗(MR)与重新给药策略(RR)用于无症状、低肿瘤负荷惰性淋巴瘤患者进行了比较。结果显示,与RR 相比MR显著改善TTTF。 利妥昔单抗扩展计划或重新治疗研究(RESORT;e4402)是一项3期...
-
儿童和年轻成人急性白血病:单vs双单位脐带血移植
环球医学资讯
2016年07月26日
点击量:278
1小时条评论据统计,目前全球脐带血移植已超过3万例。2016年6月,发表在《Blood》的一项研究比较了单vs双单位UCB移植治疗处于缓解期的急性白血病或骨髓增生异常综合征儿童和年轻成人的疗效。结果表明,具有充足细胞剂量的单UCB移植仍然是标准的治疗方法,并且TRM较低。当具有充...
-
髓系恶性肿瘤综合性基因诊断工具的开发和验证
环球医学资讯
2016年07月26日
点击量:339
1小时条评论癌症基因组学的进展已经确定了具有明确预后的众多复发性突变和/或不同癌症的治疗意义。2016年7月,发表在《Blood》的一项研究描述了髓系恶性肿瘤综合性基因诊断工具Karyogene并对此进行验证。结果显示,Karyogene是一种可靠的基因诊断平台,用于髓系恶性肿瘤的转化研...
-
减白细胞液预防同种异体输血不良反应的疗效
环球医学资讯
2016年07月25日
点击量:285
1小时条评论2015年12月,发表于《Cochrane Database Syst Rev》的一项研究考察了减白细胞液用于预防同种异体输血不良反应的疗效。 背景:输血是一种用于短期解决生命和健康威胁疾病的急性干预。但是,输血可产生不良事件,一些不良事件与潜在免疫调节或直接输送感染物质(如,...
-
辅助EGFR酪氨酸激酶抑制剂可提高非小细胞肺癌无病生…
环球医学资讯
2016年07月20日
点击量:309
1小时条评论一些小规模的临床研究表明,对于 EGFR 突变的非小细胞肺癌,术后 TKI 辅助治疗可延长患者的生存时间,然而也有研究表明术后 TKI 辅助治疗对患者预后并无影响。2016年6月,发表在《Chest》的一项荟萃分析显示,在经历完整切除EGFR突变NSCLC患者中,辅助EGFR-TKI治疗可...
-
Coltuximabravtansine联合利妥昔单抗用于DLBCL患者…
环球医学资讯
2016年07月15日
点击量:161
1小时条评论2016年6月,发表在《Br J Haematol》的一项II期、多中心、单臂研究观察了抗CD19抗体药物联合coltuximabravtansine用于复发/难治性弥漫性大B细胞淋巴瘤患者的疗效。结果显示,在复发/难治性弥漫性大B细胞淋巴瘤患者亚组中耐受好、临床响应好。 在这项II期、多中心、...
-
Elotuzumab或可使复发性/难治性多发性骨髓瘤患者获益
环球医学资讯
2016年07月15日
点击量:154
1小时条评论Elotuzumab是一种免疫刺激抗体。2016年6月,发表在《Blood》的一项概念证明、开放标签、2期研究表明,与硼替佐米联合地塞米松治疗相比,Elotuzumab+硼替佐米+地塞米松可延长复发性/难治性多发性骨髓瘤(RRMM)患者的PFS,且并不附加临床毒性。基于该2期研究结果,需...
-
多发性骨髓瘤强化治疗前VTD方案优于VCD方案
环球医学资讯
2016年07月15日
点击量:1877
1小时条评论三药联合方案广泛用于多发性骨髓瘤的治疗。2016年5月,发表在《Blood》的一项随机试验比较硼替佐米-沙利度胺-地塞米松(VTD)和硼替佐米-环磷酰胺-地塞米松(VCD)作为新诊断多发性骨髓瘤患者高剂量治疗和自体干细胞移植(ASCT)前的诱导治疗的有效性。结果表明,多...

会员登录

